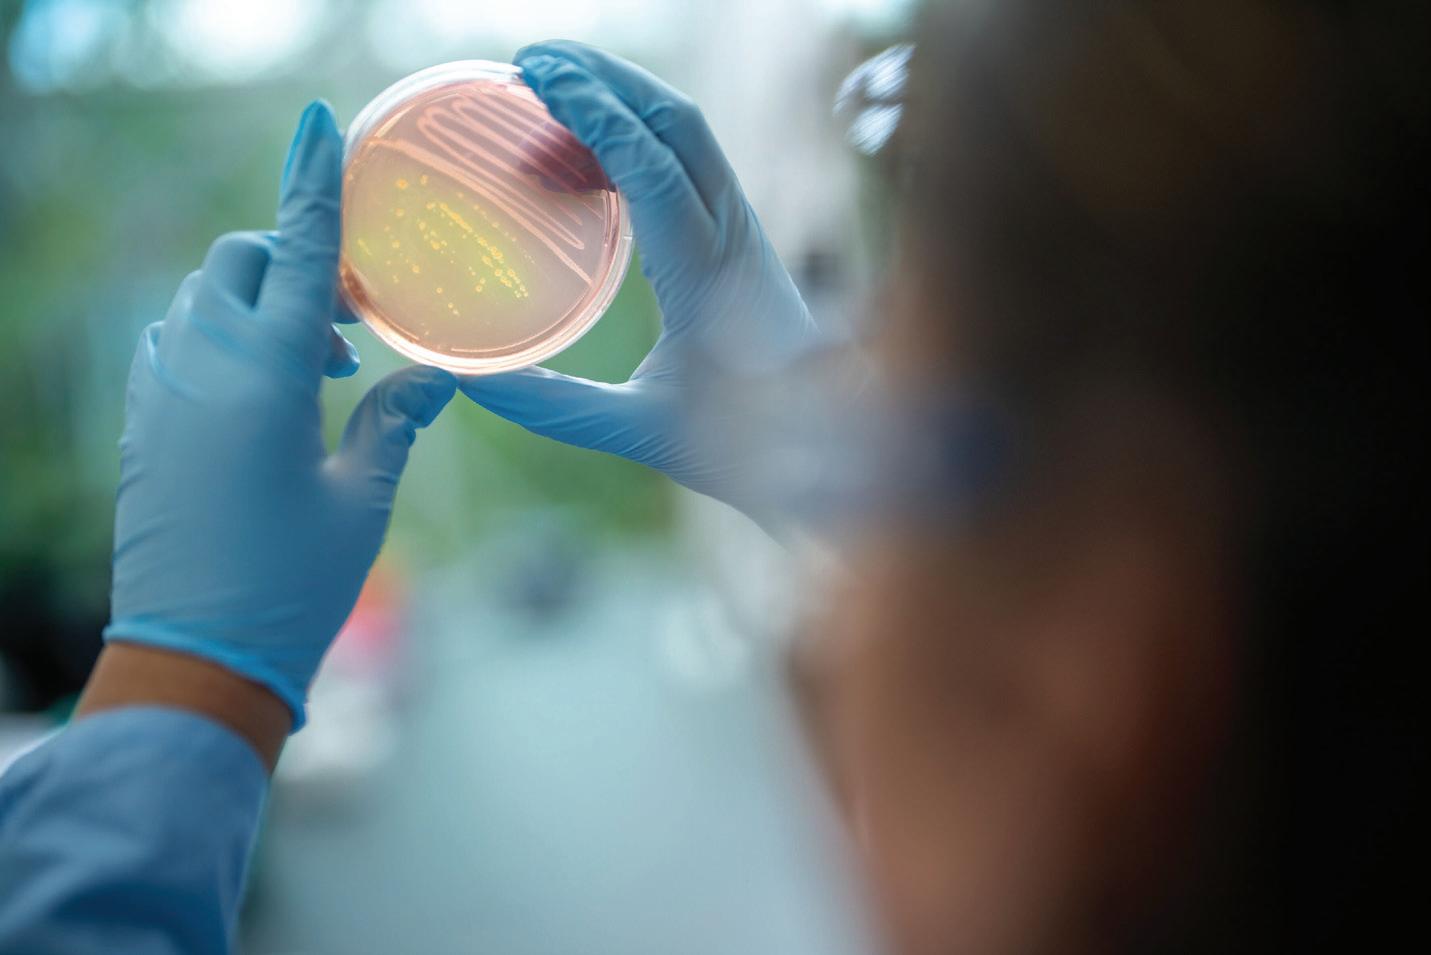

North Parker

Your Investment Creates Opportunities
From immersing herself in Chicago and making professional connections, to building a community at her Writing Center job, to studying abroad in England, senior Megan Rodda takes advantage of the wealth of opportunities available to her at North Park.
“The financial aid I receive has allowed me to pursue the things I’m passionate about without having to worry,” she said.
Your investment in the North Park Fund is a direct investment in students like Megan. The fund provides students with the financial support they need so they can discover the opportunities that await them and thrive academically. With your gift, you support every student, every day.

Winter 2026
Building Bridges of Opportunity
North Park forges partnerships throughout Chicagoland that link students to leading hospitals, labs, and universities. 20 Our Friends Overseas: Partners in Intercultural Exchange

From Sweden to South Korea, study abroad programs connect students to the world and to themselves.

Alumni open doors for students and graduates through mentorship, internships, and career guidance.

North Parker
Editorial Board
Mary K. Surridge
President
Michael Nevergall MNA ’13 Vice President for Advancement
Anthony Scola Vice President for Enrollment Management, Marketing, and Strategic Planning
Editorial Staff
Kennedy Murphy
Managing Editor
Ellen Almer BA ’94
Ana Funduk
Lindsey Post Robinson BS ’05
Editors
Ellen Almer
Ana Funduk
Heather Hobbs
Andrew Meyer BA ’06, MA ’13
Kennedy Murphy
Eileen O’Gorman
Lindsey Post Robinson
Jared Scott Tesler
Writers
Design Staff
Susannah Kim
Art Direction and Design
Karamel Aguila
Graphic Designer
Phil Dembinski
Jason Lindsey
Karl Soderstrom BS ’93, MA ’95
Edgar Torres MA ’16
The North Parker is published twice a year for alumni and friends of North Park University, 3225 West Foster Avenue, Chicago, Illinois 60625-4895. For mailing list adjustments, questions, or suggestions, please contact the Office of Alumni Engagement at (773) 244-4750.
First Word

Lifelong relationships and enduring partnerships are two of the common threads woven throughout the fabric of North Park’s history, which pave the way for the continued growth and thriving of our university. In this issue of the North Parker —celebrating 90 years of publication—we highlight some of those valued partnerships, along with significant milestones.
First, thank you for your love and loyalty to North Park. The lifelong relationships you formed during your years here have inspired your partnership in ways that have sustained our mission and supported our students over many years. Your support is increasingly essential for our future; faithful alumni and friends are our great strength in this challenging world of higher education, which evolves daily. We are grateful for your prayers and partnership.
I believe our founding mission remains a relevant and compelling mission today. Rooted in a commitment
to faith and service, the Evangelical Covenant Church—celebrating 140 years—founded North Park as an institute of higher learning for first-generation immigrant students to advance faith, education, and professional opportunities for the generations to follow. As we advance our mission and invest in the success of our students today, we are proud to be accelerating and elevating our U.S. News & World Report rankings in Social Mobility (#6) and Best Value (#25) for regional universities in the Midwest.
In the pages that follow, you will enjoy photos of the 100th Homecoming celebration and read about North Park’s honoring of a 50-year relationship with our partner campus Södra Vätterbygdens Fölkhögskola in Jönköping, Sweden, with the bestowing of North Park’s highest honor, the David Nyvall Medallion for Outstanding Service and Partnership. For half a century, this relationship has offered
I thank my God every time I remember you.
Philippians 1:3
students a unique opportunity to explore faith, culture, and learning in a truly global context. It stands as a testament to the power of shared vision across borders and traditions.
You’ll also read about the bonds we are strengthening with other international and local universities to advance student success and how our alumni serve as mentors to their fellow North Parkers.
We also celebrate the vibrant spirit and achievements of Viking athletics. Our student-athletes continue to embody a culture of champions—competing with excellence, integrity, and heart. We’re especially proud to honor legendary men’s basketball coach Dan McCarrell NPC ’61, whose recent induction into the Small College Basketball Hall of Fame reflects his impact on the court and his legacy in shaping lives.
These milestones are not only historical markers—they are living reminders of who we are and who we are becoming. I invite you to read every word in this issue and join us in honoring the people and partnerships that continue to shape North Park’s story.
With gratitude for your faithfulness,

Mary K. Surridge President

Members of one of North Park University’s largest incoming classes bond during a Threshold event in downtown Chicago.

Across Campus

North Park Rises in Rankings
North Park University (NPU) welcomed 563 students in the fall 2025 traditional undergraduate class, 453 of whom are firstyear students. NPU also received commendable rankings in the U.S. News and World Report 2026 lists, rising to #54 in the Best Regional Universities in the Midwest category and #6 in the Social Mobility subcategory, as well as being listed in the Best Value subcategory for the first time in recent years at #25.


New Appointments Strengthen North Park’s Leadership Team
This fall, Vice President for Student Engagement Dr. Francisco “Frank” X. Gaytán was named vice provost alongside his other duties. In partnership with Provost Michael Carr, Gaytán serves as chief architect for student success and retention. Anthony Scola was appointed vice president for enrollment management, marketing, and strategic planning. In addition to his previous responsibilities, Scola now oversees North Park’s internal strategic planning process, initiatives, and accountability.
Community Music Academy Teaches Music to Local Youth
North Park began its Community Music Academy this fall, offering violin lessons to students ages 5–18. “We provide a unique opportunity for the local youth to work with a university professor in our state-of-the-art facilities,” said Professor Jennifer Dunne. “Musical education allows students to attain concentration skills, develop high self-esteem, and experience the joy of music.”

Alumna Speaks at White Coat Ceremony
Dr. Janice Phillips BS ’76, assistant director of the Illinois Department of Public Health, helped honor about 80 nursing students in the undergraduate and graduate programs as they received their white coats in preparation for starting their clinical rotations. “You’re now entering the next phase of your three-step career: You learn, you earn, you return,” said Phillips, who earned her own white coat at North Park almost 50 years ago. “Thankfully, you are in a stellar nursing program that will prepare you to pursue a demanding and honorable profession.”
Helping End Student Housing Insecurity
North Park received a $142,216 grant from the Illinois Board of Higher Education (IBHE) that provided 45 students with food, housing during academic breaks, textbooks, technology access, and other basic needs. The grant, issued by IBHE’s End Student Housing Insecurity grant program, funded a staff position and food pantry, according to Skyy Barney, NPU’s student care coordinator.

Welcome New Faculty
Dr. Titilope Banji Assistant Professor of Mechanical Engineering
Dr. April Demito Associate Professor and Graduate Nursing Program Director
Dr. Clement Essien Assistant Professor of Computer Science
Dr. Aidé Hernandez Assistant Professor of Sociology
Dr. Cecilea Mun Assistant Professor of Philosophy
Dr. Anne Richter
Assistant Professor of Nursing, DEMSN
David Williams
Assistant Professor of Nursing, DEMSN
Dr. Caitlin Wong Hickernell
Assistant Professor of Biology

Viking Football Players Honored Nationally
Senior safety Ben Butler, senior wide receiver Jereme Ombogo, and junior defensive back Amare Johnson earned national recognition this fall when they were named to the D3football.com National Team of the Week. Butler received honors in weeks one and three.
Recent Graduate Named Lincoln Academy Student Laureate
The Lincoln Academy of Illinois named Sofia Grivot Volkmann BS ’25 North Park’s 2025 Lincoln Academy Student Laureate, recognizing her excellence in curricular and extracurricular activities. Grivot Volkmann majored in biomedical sciences, engaged in advanced scientific research across several disciplines while at NPU, and plans to pursue an MD/PhD. She also earned all-conference honors in track and field and cross country.
NPU Hosts Third Annual Van Der Meid Lecture
Dr. John Inazu, Sally D. Danforth Distinguished Professor of Law and Religion at Washington University in St. Louis, spoke to students about his book Learning to Disagree: The Surprising Path to Navigating Differences with Empathy and Respect at the third annual Van Der Meid Lecture in American Politics. The lecture is named in honor of Theodore “Ted” Van Der Meid BA ’79.
Coach Dan McCarrell Honored in Hall of Fame
On October 31, former NPU Head Men’s Basketball Coach Dan McCarrell NPC ’61 was inducted into the Small College Basketball Hall of Fame in Lakeland, Florida. A three-time Coach of the Year, McCarrell led the Vikings to three straight national titles (1978–80). He coached nine All-Americans, sent four players to the NBA, and left a legacy of excellence, leadership, and tradition in NCAA Division III basketball.

North Park Launches Redesigned University and Seminary Websites
In October, North Park launched a fully redesigned website for both the university and seminary, offering a fresh look and an improved user experience for prospective and current students, alumni, and the broader community. The new sites also have muchimproved mobile functionality.

Lives of Significance and Service in Action
North Park’s annual Service Day took place on September 13. More than 200 students, alumni, faculty, and staff visited 17 sites around Chicago to volunteer with nonprofit and civic agencies. “This day provides a way to put into practice our value of living lives of service,” said Andrea Spicer, coordinator for local service outreach. “Witnessing hundreds of people connect and work alongside our neighbors was a meaningful expression of North Park showing up in ways that impacted everyone involved.”

North Park Honors Sister School with Award and Alumni Trip
In May, NPU awarded its highest service honor to Södra Vätterbygdens Folkhögskola (SVF), the David Nyvall Medallion for Service and Partnership, celebrating 50 years of student exchange. The NPU-SVF College Line Exchange Program is the longest continuous international exchange program between the United States and Sweden. To mark the occasion, a group of NPU alumni and families took a 12-day trip across Denmark and Sweden, including an extended visit to SVF’s hometown, Jönköping.
MEET THE STAFF
Turning Ideas into Impact
When North Park University (NPU) and North Park Theological Seminary faculty envision bold new projects to enhance student learning or engagement, they rarely take the journey alone. Alongside them walk Director of Sponsored Projects Renee Cox and Senior Grants Accountant Chris Bakker MBA ’25, the small powerhouse behind the scenes dedicated to helping those big ideas come to life.
Cox handles what she calls the “preaward” side of things. She’s the first stop for faculty searching for grants, guiding them as they draft proposals and navigate complex requirements. “It’s their project; they know it best,” she explained, “but we help with budgets, guidelines, and approvals so their ideas can move forward.”
Once a proposal is funded, Bakker takes over. He manages the “postaward” work: tracking expenses, filing reports, and ensuring each grant stays in compliance. His role frees faculty to focus on the heart of their work. “If a professor knows everything about biology but nothing about procurement, that’s where I come in,” he said with a smile.
Their collaboration has helped fuel tremendous growth. NPU now manages more than 20 active grants, ranging from National Science Foundation projects in STEM education to Lilly Endowment initiatives in ministry and seminary life. More than 90 students have received support from grants in the form of student wages for research or grant-related work, stipends, or grant-funded scholarships in 2024–25. However, navigating the current landscape hasn’t been without chal-
lenges. Political uncertainty, shifting federal budgets, and executive orders paused certain projects this year. Thankfully, many were later greenlighted.
Cox and Bakker have relied on their colleagues in the Provost’s and Business Offices, along with strong professional networks and careful planning, to stay ahead. “Even with regulations and funding changes, we focus on what matters: student impact,” Cox noted.
Some of the most meaningful projects are not the largest but the most personal. One state-funded grant pro -
vided food, housing, and technology to students facing financial insecurity. For Cox and Bakker, seeing a grant directly meet basic student needs underscores the real-world power of their work.
“Those stories remind us why our work matters,” Cox said. Together, she and Bakker form the bridge between vision and reality—partners in ensuring that North Park’s mission is lived out in tangible ways. Their collaborative work demonstrates how faculty-driven innovation, carefully managed and executed, transforms student lives.

Renee Cox and Chris Bakker
MEET THE FACULTY
Preparing Students to Make a Better World
Dr. Peter K. B. St. Jean MA ’22, MOL ’24 became the dean of the College of Arts and Sciences (CAS) at North Park University in 2024 after serving as interim co-dean. He brings a new vision to CAS, which he describes as the “heartbeat, not just of North Park, but of a liberal arts education.”
St. Jean’s time as dean has been devoted to developing initiatives to better prepare students for lives of significance and service. These include events to welcome students and grow camaraderie, the creation of a student council and newspaper, and opportunities to help students visualize and pursue their futures by connecting with graduate programs, employers, and alumni.
In addition to serving as an advocate and mentor for students and faculty, St. Jean is a tenured sociology professor. Through his teaching, he shares his knowledge from extensive scholastic experience, including a PhD in Sociology and a Master of Arts in Criminology, as well as lessons learned through his role as a clinical mental health counselor and his past military service.
“My life’s mission is to reduce suffering and improve quality of life. North Park’s mission fits very squarely—almost like hand in glove—in my own,” he said.
St. Jean sees the goal of the CAS faculty and staff, and of the students themselves, as trifold: for students to discover who they are and who they are not, to know where in life they fit,

and to know who they are becoming. Of this, he said, “Can you imagine if we give that gift to the world?”
The skills students cultivate in CAS classes allow them to develop multiple competencies and pivot seamlessly in the future.
He explained, “We not only prepare students to have a chance of excelling in all the majors that already exist at the university, but we also prepare them to excel in professions that have not yet even been considered.”
North Park’s mission fits very squarely—almost like hand in glove—in my own.
SEMINARY SPOTLIGHT
An Intercultural Approach to Ministry

“We learn by listening to one another—from within our cultures and cross-culturally as well,” said Dr. J. Nathan Clayton.
Clayton speaks from personal experience. Before pursuing his biblical teaching ministry at North Park Theological Seminary (NPTS), he was raised in France as a missionary kid, his parents serving in theological education across Europe, Africa, and the Middle East. He spent his formative
years surrounded by many cultures in the evangelical French church and beyond.
These days, Clayton brings his intercultural background and understanding of diverse ministry settings to his role as associate professor of Old Testament and chair of the Bible field, helping students faithfully engage in the historical and grammatical interpretation of God’s Word.
“I grew up learning different lan-
We learn by listening to one another—from within our cultures and crossculturally as well.
guages and being exposed to many Christian ministry and worship traditions,” explained Clayton, whose artifacts from biblical sites and other cross-cultural mission trips are displayed in his office.
“God has shaped me in these unique ways, as He has called me to teach at North Park, where I have the joy of interacting with students from a wonderful variety of cultures from around the country and the world,” he said.
A travel course based in the Democratic Republic of the Congo is where Clayton said he found his “sweet spot,” co-teaching—with Professor of Missiology Dr. Paul De Neui—a combined class of North Park and Congolese students in both English and French.
Clayton enjoys teaching in every way, including in-person mini-case studies, prerecorded video lectures, small-group discussions in digital breakout rooms, and tours of the University of Chicago’s Institute for the Study of Ancient Cultures, West Asia & North Africa.
“In all of these formats, I seek to bring students in contact with the living Word of God,” he said, “by helping them get a sense of the clear flow of biblical history, grow in their ability to recognize and interpret various literary genres and canonical contexts, and faithfully build a bridge from the past meaning of Scripture to its present significance in ministry.”

STUDENT SPOTLIGHT
From Campus to Clinic: Nursing Partnerships in Practice
Every month on a Monday in Carlson Tower, a group of nearly 50 students meets to network, study, and enjoy each other’s company.
Student Nursing Association (SNA) is North Park University’s chapter of the National Student Nurses’ Association, which encourages students interested in nursing to get involved in local healthcare and hospital settings.
“Being a nursing major can be difficult at times, and it’s nice to have a group of people to keep you grounded and bond with over hard classes,” said
Matthew Bonto, fourth-year nursing student and head of public relations for SNA.
The group pairs first- and secondyear students with third- and fourthyear students for mentorship and develops relationships with local hospitals and nonprofits such as Vitalant, Endeavor Health, and Ann & Robert H. Lurie Children’s Hospital of Chicago.
Through these relationships, SNA hosts blood drives, coordinates alumni panels, and recommends internships and positions to nursing students. In October, SNA partnered with Lurie Children’s Hospital to organize and promote a donation drive for Childhood Cancer Awareness Month.
“North Park is all about community, which helps our members see what careers are available to them in the nursing field,” said Mary Elizabeth
Guilbert BSN ’25, former SNA president.
In addition to outside partnerships, the group values time together to relax and focus on things other than academics. Each year, they host holiday parties and other outings to ensure members avoid burnout in their rigorous degree program.
“We hold each other accountable for our learning,” Bonto said. “If you’re struggling in a certain area, there’s going to be someone in SNA who aced that subject and is willing to sit and explain it to you.”
Both Bonto and Guilbert said these internal relationships and external partnerships broaden their perspectives on what nursing can look like post-graduation, and they look forward to SNA sharing that with North Park nursing cohorts to come.
VIKING STRONG
A Culture of Champions

For Karl Soderstrom BS ’93, MA ’95, North Park University’s (NPU) recently retired women’s tennis coach, the beauty of NCAA Division III athletics lies in its lived purpose.
“Our programs have preserved the purpose of college athletics: to be part of the holistic formation of young adults who compete, study, and grow together,” said Soderstrom, who is also a professor of philosophy.
And in these formative experiences, teams might earn some hardware
along the way. Under Soderstrom’s leadership, the women’s tennis team shared the 2024 College Conference of Illinois and Wisconsin (CCIW) title, a first in program history.
It’s just one of several recent firsts at North Park. Last April, the dance team won its inaugural NCAA Division III Team Performance category title at the College Classic National Championship. Head Coach Kim Maljak credited the team’s incredible work ethic for the win.
Our programs have preserved the purpose of college athletics: to be part of the holistic formation of young adults who compete, study, and grow together.
—Karl Soderstrom
Their championship followed closely on the heels of another winning team—women’s volleyball won backto-back CCIW Tournament Championships in 2022 and 2023, with the 2022 title being the program’s first. Head Coach Michael Sopocy said that his student-athletes share the same values and mindset.
“If you are on the court, you are competing to keep your spot,” Sopocy said. “If you’re off it, you compete to get out there and make your teammates better.”
He also said the entire NPU community contributes to his team’s success. “North Park is a family. When we’re on the court, it feels like the whole campus is out there to help us compete. We are all there for each other.”
North Park has a rich history of winning together. In 2017, the men’s soccer team went on a historic run, reaching the Division III championship, where they lost to powerhouse Messiah University in a 1–2 nailbiter.
The Vikings were fresh off a dramatic shoot-out victory in their semifinal matchup against the University of Chicago.
Despite the loss, then-coach John Born, current assistant vice president for athletics and sport management, credited their success to the diversity of the team and their desire to come

North Park University Athletics programs— from tennis to football—nurture well-rounded student-athletes.

together for something greater than themselves. At a particular pre-game banquet, Born said that his studentathletes, dressed in matching blueand-yellow ties, stood out from the other schools.
“When I looked at our group, smiling and matching, I saw a team.”
One cannot discuss NPU’s athletic prowess without including its men’s basketball dynasty of the late 1970s and mid-1980s. During this epic period, the team secured Division III titles from 1978–80, then again in 1985 and 1987. This earned Dan McCarrell NPC ’61, North Park’s beloved coach during the 1978–80 run, a place in the Small College Basketball Hall of Fame in October.
“Whenever we talk about the history and tradition of this program, Coach McCarrell and his teams are our gold standard,” said current Head Men’s Basketball Coach Edwind McGhee McCarrell’s legacy has lived on, with today’s coaches stating their commitment to creating well-rounded student-athletes who lead successful post-graduate lives.
“Our program’s number one goal is for our athletes to earn a North Park degree,” said Head Football Coach Kyle Rooker. “We stress the importance of going to class, developing relationships with professors, and doing the daily work. At the end of the day, academics will take these young men farther than football. Not coincidentally, most of our best players are some of our best students.”
As for women’s tennis, Soderstrom is leaving the team in the capable hands of his former assistant coach Alice Copland MOL ’21, who plans to continue his—and North Park’s—legacy of excellence, both on the court and in the classroom.
Viking Strong
BUILDING BRIDGES OF OPPORTUNITY

NORTH PARK PROFESSORS WORK TO STRENGTHEN BONDS WITH OTHER INSTITUTIONS, PAVING A PATH TOWARD SUCCESS FOR
STUDENTS.
By Ellen Almer BA ’94
In 2022, North Park University (NPU) Professor of Biology Dr. Timothy Lin invited a colleague from Northwestern University’s Center for Synthetic Biology to talk to his students about careers in biotechnology and solving societal issues with synthetic biology. He never imagined that meeting would evolve into a thriving academic partnership between the two schools.
“She was very impressed by the caliber of the questions our students asked,” Lin said of Dr. Danielle Tullman-Ercek, director of Northwestern’s Master of Science in Biotechnology program and professor of chemical and biological engineering. She was so impressed, in fact, that she invited one of the students to work in her lab that summer.
It was the beginning of what has proven to be a fruitful partnership.
This past spring, North Park and Northwestern began a program in which up to two NPU molecular biology and biotechnology (MBBT) majors—selected from a pool of about 10 MBBT majors eligible to apply—will intern in TullmanErcek’s lab each year, assisting in cutting-edge research and earning credit toward graduation.
The work at Northwestern’s Center for Synthetic Biology touches on everything from advancements in medical therapies to consumer products and environmental testing.
“We wanted to provide the opportunity to North Park undergraduate students—particularly given that many are local to Chicago—to research at Northwestern to give
them a feel for what research at an R1 institution is like,” said TullmanErcek. The R1 designation refers to universities that spend at least $50 million on research and development and award at least 70 doctorates per year.
For Lin, it was an opportunity to let NPU students shine in a bigger arena.
“As a professor, you train students to excel and identify ones who especially make North Park shine,” Lin said. “Then, you grab the opportunities that come your way to make things happen for them and the university.”
In recent years, North Park has taken advantage of its location in Chicago to cultivate partnerships
“WE WANTED TO PROVIDE THE OPPORTUNITY TO NORTH PARK UNDERGRADUATE STUDENTS ... TO RESEARCH AT NORTHWESTERN TO GIVE THEM A FEEL FOR WHAT RESEARCH AT AN R1 INSTITUTION IS LIKE.”
—DANIELLE TULLMAN-ERCEK

“OUR CONNECTIONS WITH VARIOUS CLINICAL LOCATIONS THROUGHOUT THE CITY ... ARE COMPELLING TO THOSE PURSUING CAREERS IN ATHLETIC TRAINING.” —ANDREW LUNDGREN
for other medical field programs as well.
One such example is a unique alliance between NPU and Roosevelt University’s College of Science, Health and Pharmacy, in which firstyear North Park students can earn a Bachelor of Arts in Biochemistry and a Doctor of Pharmacy in a total of six years—an entire year sooner than the traditional seven.
Another partnership is North Park’s affiliation agreement with Illinois College.
Through this agreement, North Park guarantees admission each academic year to two Illinois College graduates into its Master of Science in Athletic Training (MSAT) program. Illinois College faculty are responsible for recommending candidates for these two reserved spots. Once nominated, the selected students must still complete the standard application process required of all MSAT applicants.
“Our location in Chicago is definitely a bonus,” said Andrew Lund-
gren MA ’01, North Park’s athletic training program director and an associate professor of athletic training. “Our connections with various clinical locations throughout the city and professional sports teams are compelling to those pursuing careers in athletic training.”
Collaborating with reputable institutions enables NPU to attract highly qualified applicants, said Lundgren, who is currently exploring additional partnership opportunities.
Also in the School of Nursing and Health Sciences, North Park places its nursing majors in magnet-designated hospitals for their clinical rotations. The Magnet Recognition Program from the American Nurses Credentialing Center acknowledges healthcare organizations with excellent nurses and outstanding
NORTH PARK’S PARTNERSHIPS WITH SUCH HOSPITALS THROUGHOUT CHICAGOLAND—LIKE ANN & ROBERT H. LURIE CHILDREN’S HOSPITAL OF CHICAGO, ENDEAVOR HEALTH SWEDISH HOSPITAL, AND NORTHWESTERN MEMORIAL HOSPITAL—SET ITS STUDENTS UP FOR CAREER SUCCESS FOLLOWING GRADUATION.
work environments. It is the gold standard for nursing practice and patient care.
North Park’s partnerships with such hospitals throughout Chicagoland—like Ann & Robert H. Lurie Children’s Hospital of Chicago, Endeavor Health Swedish Hospital, and Northwestern Memorial Hospital—set its students up for career
success following graduation.
Beyond the STEM field, NPU partners with local community colleges—including Triton College, the College of DuPage, and the College of Lake County—to guarantee its students transfer admission to North Park. As part of the program, North Park’s admissions counselors assist in transferring students’
credits to ensure they complete their bachelor’s degrees as quickly as possible.
“The partnership is mutually beneficial,” said Malcolm Parker MOL ’22, North Park’s associate director of transfer admissions. “Transfer agreements remove doubts and provide clarity for transfer students who want to earn a bachelor’s degree. Our goal at North Park is to open doors so our transfer students have a clear pathway to pursue lives of significance and service.”
After more than 130 years as a fixture in Chicago, NPU has built a reputation for excellence in preparing students for lives of significance and service. The partnerships that have grown from that reputation have cemented North Park as one of the leading educational institutions in the city.


Our Friends Overseas: Partners in Intercultural Exchange
Rooted in a heritage of cultural exchange, North Park fosters understanding and opportunity through international partnerships.
By Jared Scott Tesler
Present worldwide, North Park University’s (NPU) study abroad and international exchange programs provide students with rich opportunities to learn and grow—academically and person-

ally—and highlight the university’s long-standing commitment to interculturalism as well as its bilateral partnerships with foreign institutions such as Liverpool Hope University (LHU) in Liverpool, England; Sungkyunkwan University in Seoul, South Korea; and Södra Vätterbygdens Folkhögskola (SVF) in Jönköping, Sweden.
In 1976, North Park joined forces with SVF to establish what is now the longest-running exchange program between an American and Swedish school. The 50-year partnership honors NPU’s Swedish American roots.
“We were founded by Swedish immigrants who were very attentive to the need to navigate two different cultures,” explained Vice President for Student Engagement and Vice
“Spending a semester or summer abroad promotes global citizenship by encouraging students to engage with new worldviews, cultures, religions, and languages. When they spend time in a different country, students gain a more nuanced understanding of their own identity and culture.”
—Tessa Zanoni
Provost Dr. Francisco “Frank” X. Gaytán.
“Our founding president, David Nyvall, a Swedish immigrant himself, spoke about the need to nurture one’s own culture as well as the importance of embracing other cultures,” he said. “Study abroad opens students’ eyes to a world of opportunity, enabling them to intentionally push their boundaries, which is increasingly important in a globalized and interconnected world.”
Director of the Office of International Affairs Tessa Zanoni said that besides enriching academic and personal development for North Park students who travel abroad and exchange students who come to study in Chicago, such partnerships can also create career opportunities and
professional networks for graduates.
“Spending a semester or summer abroad promotes global citizenship by encouraging students to engage with new worldviews, cultures, religions, and languages. When they spend time in a different country, students gain a more nuanced understanding of their own identity and culture,” she said. “Those who have participated in our exchange programs have gone on to live and work abroad or pursue amazing careers or further education here in the United States.”
This past February, Assistant Director of International Affairs Ruby Regina Benigno spent four days visiting LHU, where she met with staff, toured campus facilities, and discovered firsthand why North Park students have fallen in love with Liverpool.
“I understand that leaving the familiar comfort of your home country and culture to study abroad is often hard and stressful, but I want to reassure students that any challenges are worth it for what will be a wonderful time in their lives.”
—Wrigley Crabtree

“It’s important to be able to visit our study abroad sites to better advise prospective students,” she said. “Our partnerships with foreign institutions give students the opportunity to study abroad in an environment with ample support, where we’ve developed a deep working relationship. When we send students to institutions where we truly know their staff, we can better prepare them to go abroad and make sure we communicate their needs to our partners.”
Marcus Wester BA ’25, an international student from Sweden, spent two consecutive semesters at LHU while pursuing his bachelor’s degree in business at NPU. He learned about British history and culture, completed courses in marketing and economics, and even enjoyed three days of kayaking, zip-lining, and spelunking in Wales.
“Experiencing two very different university environments was exciting and eye-opening. The contrasts made my experiences and memories feel more unique and added value to me personally,” Wester said. “I gained a deep connection with multiple places and people, broadened my perspective, grew my confidence, and—of course—have plenty of stories to tell.”
As part of a May mini-term program, Jaliyah Conway, a third-year student double-majoring in finance and sport management, spent three weeks studying global business at LHU, where she became immersed in discussions about economics, finance, and marketing and how they apply to soccer, one of England’s most popular sports.
The people, she said, helped make her experience truly unforgettable.
“Everyone was lovely and helpful, from classmates studying abroad, to students who attend LHU year-round,
to staff, to residents. I felt welcome from the moment I arrived,” Conway recalled. “This experience helped me grow so much and gave me a deeper perspective on life.”
Senior Wrigley Crabtree spent the second semester of her sophomore year abroad at Sungkyunkwan University. A double-major in psychology and communications, she took courses in media literacy, Korean language, Korean culture and politics, and East Asian art.
Crabtree also traveled to Japan, Taiwan, and the Philippines and enjoyed hiking after class; wearing traditional South Korean clothing; sampling a classic and popular dish called dak-galbi; and singing with friends at noraebangs, private karaoke rooms that are a key part of Korean culture.
“Coming back to North Park, I had an increased sense of confidence,” she said. “I gained a deeper layer of empathy for people from different cultures. And I encountered so many things that I didn’t understand, which made me eager and excited to learn more!”
This fall, Crabtree had the opportunity to apply the real-world lessons and skills from her time abroad to her new role as an international student orientation leader.
“I understand that leaving the familiar comfort of your home country and culture to study abroad is often hard and stressful,” Crabtree said, “but I want to reassure students that any challenges are worth it for what will be a wonderful time in their lives.”

PAYING IT FORWARD
North Park alumni give their time and talent and ask others to follow suit.
By Ellen Almer BA ’94
Several decades after leaving North Park University (NPU) with a business degree, Tom Bagley BA ’74 returned to talk to alumni about his thriving career in private equity. In attendance was Professor of Finance Dr. Alvin Kamienski, who soon realized that the deeply informative three-hour lecture would be perfect for NPU’s business majors.
The next year, Bagley’s audience shifted from alumni to students, who, dressed in smart business attire, gathered in a conference room in downtown Chicago to mimic a real-world work environment.
That meeting ignited a valuable
partnership between NPU and Bagley that has nurtured numerous careers.
Bagley, founder of Pfingsten Partners LLC, said he has hired as many as 10 North Parkers at his various places of employment and is viewed by many as an early pioneer in private equity. In a field dominated by those with Ivy League educations and family connections, Bagley had to work harder and smarter than most others to succeed.
He said he learned his work ethic at North Park, which is why he has hired so many NPU graduates.
“Having gone through North Park myself, I knew they were getting a
good education,” Bagley said. “And one of the things I valued about my time there was that I wasn’t told what to think; I was taught how to think. North Park teaches critical problem solving.”
Another benefit of an NPU education, especially when trying to succeed in a business built on trust?
“North Parkers tend to have a good moral compass,” said Bagley, who in 2014 received NPU’s Distinguished Alumni Award. “When you combine the ability to think with the drive to do the right thing, even when no one is looking, that is integrity. And that is appealing to me in an employee.”
“I tell them, ‘You don’t owe me anything; just pay it forward. Once you’re in a position where you’ve had some success, it’s now your responsibility to become the mentor.’”
—Tom Bagley
One of Bagley’s NPU hires was Janice Erickson BA ’83, with whom Bagley still exchanges Christmas cards. After her graduation, Bagley hired Erickson to work for him at the former bank holding group Citicorp, now known as Citigroup.
Even after Erickson moved on to another job, she routinely sought career advice from Bagley.
“Several years ago, I was looking for a new job and reached out to Tom,” Erickson said. “We sat together and brainstormed roles I could pursue. He helped me think of positions that would use the skills I’d developed over the years.”
Eventually, Bagley referred her to a
past coworker, who then referred her to a contact that led to her current job at Antares Capital LP.
“I felt very blessed that Tom and others would take the time to think through opportunities with me along the way,” Erickson said.
Other talented alumni, like Lawrence Anderson BA ’71, bring their skills and counsel to NPU via an Evangelical Covenant Church connection. Anderson worked for 23 years as a sales and marketing executive for three of the world’s largest financial futures firms before running Covenant Ministries of Benevolence (CMB) from 2008 until his retirement in 2018.
Anderson, who in 2004 was given NPU’s Distinguished Alumni Award, estimated that he’s guided more than 100 North Park students onto their career paths via internships and career counseling.
“What I’ve enjoyed most are the ties between CMB and North Park,” said Anderson. “Nothing excites me more than to see North Park’s success.”
Anderson mentored and hired Scott Hanson BA ’06, CMB’s senior vice president of finance, and Scott Stenmark BA ’91, NPU’s vice president for finance and administration.
“Larry has been a great friend and mentor to me for many years,” Stenmark said. “He embodies the North Park mission of living a life of significance and service.”
NPU’s partnerships extend beyond the business field. The athletic training program continues to help its graduates find jobs with its long-term partners.
Marcus Malou MS ’24, did his clinical intensive placement at Lane Tech College Prep High School through NPU’s partnership with ATI Physical Therapy and Chicago Public Schools (CPS). He’s now an ATI employee who primarily serves as an athletic trainer within CPS.
Since earning her degree, Melissa Martinez MS ’22 has worked at three institutions with which NPU has clinical education relationships: Concordia University Chicago, Northwestern University, and Niles Township High School District 219.
And those are just a few examples, according to Dr. Alyssa Anderson BS ’12, athletic training clinical education coordinator.
“Our clinical partnerships with organizations and individuals provide a strong network in Chicagoland,” said Anderson. “Our program’s reputation
means that employers often reach out to our faculty to see if we have any graduates or alumni who may be a good fit for their open positions.”
Kamienski said the value of an alum mentor is especially important in the age of artificial intelligence. When students send their résumés to employers, computer filters often eliminate them before a human sees them.
“The best thing a student can have is someone who gets to know them throughout their career and provides coaching after they graduate,” Kamienski said. “Then, you have each other’s name in mind when you need a contact; it’s the original, in-person LinkedIn.”
Bagley said his mentees often ask how they can pay him back. “I tell them, ‘You don’t owe me anything; just pay it forward. Once you’re in a position where you’ve had some success, it’s now your responsibility to become the mentor.’”
“The best thing a student can have is someone who gets to know them throughout their career and provides coaching after they graduate. Then, you have each other’s name in mind when you need a contact; it’s the original, in-person LinkedIn.”
—Alvin Kamienski
Homecoming 2025
1 | North Park University celebrated its 100th Homecoming.
2 | Students hold up their first-place certificate for the annual 5K.
3 | Riding the mechanical bull at the Homecoming Festival.
4 | The Homecoming Festival featured a petting zoo.
5 | Welcoming Vikings in front of Old Main.
6 | North Park squared off against Augustana.
7 | Soccer players get into the spirit.
8 | A caricature artist at work at the Homecoming Festival.
9 | Alumni cheer on their team.









ALUMNI SPOTLIGHT
Healing Through Music
Trevor Nicholas BME ’08 has long been interested in music’s power to heal. After traumatic events in his youth, music became a refuge. As a music educator, he extends that refuge to his students.
“My career has been a snowball of gathering partnerships and like-minded people to make a difference in students’ lives, leading them into their communities to make everyone’s lives a little better,” Nicholas said.
His time at North Park University helped build lasting connections while growing his skills, providing a pathway where he could take composition lessons and participate in musical ensembles. These skills strengthened his repertoire, allowing him to later adjust and compose music for his students’ voices, model different instruments, and lead student ensembles.
He credits North Park’s former director of music education and choral programs, Dr. Rollo Dilworth—a wellknown and prolific choral composer—

with changing the course of his life. “He’s still a mentor of mine today,” Nicholas said.
A renowned composer and educator in his own right, Nicholas is a twotime Grammy Music Educator Award finalist and a 2025 Golden Apple Awards for Excellence in Teaching finalist.
for UNICEF USA.
Over the years, his partnerships with the likes of the Lyric Opera of Chicago, the Chicago Cubs, and Yo-Yo Ma have earned more than $600,000 in grants and opportunities for students.
My career has been a snowball of gathering partnerships and like-minded people to make a difference in students’ lives, leading them into their communities to make everyone’s lives a little better.
He has continuously grown and healed his community through music. During the COVID-19 pandemic, Nicholas led students, alumni, staff, and arts partners in a trauma-responsive music video project featuring his original composition, raising $2,200,000
To further broaden his impact, Nicholas has begun fully funded doctoral studies in Northwestern University’s music education program to research the intersection of music and healing. He said, “I want to pursue curiosities in partnership with those already doing the work, adding to that work with joy.”
North Park Fosters
Nurse’s Passion for Educating ALUMNI SPOTLIGHT
Ivana Chmielewski BSN ’18, MSN ’23, a clinical nurse educator, takes her breaks at Endeavor Health surrounded almost entirely by North Park University (NPU) alumni.
Chmielewski, who grew up in the Chicago area, is nearly a triple North Parker herself, earning her bachelor’s and master’s in nursing at NPU and
now studying for her Doctor of Nursing Practice at the university, too. She said she chose NPU immediately following her first campus visit.
“My cousin committed to North Park, and she and I were going out to lunch, but she needed to drop off some paperwork first,” Chmielewski said. “As soon as I stepped foot on campus, I called my mom and said, ‘I need to go here; I need to go to North Park.’”
Chmielewski earned the Dr. Joan E. Zetterlund Award in Graduate Nursing while pursuing her master’s degree and a prestigious Schweitzer Fellowship shortly after. As a fellow,

she developed a literacy education program focusing on the foundations of healthcare that brought nursing resources to immigrants, refugees, and minority communities. She is still active with the program and serves as a mentor for current fellows.
“Creating a coalition of resources currently unavailable to disadvantaged groups helps build connections with their community and trust with healthcare providers,” Chmielewski said.
She’s especially grateful for her professors, many of whom she’s been learning from since her first year of undergraduate studies. Chmielewski said Dr. Keith Bakken BSN ’85, MSN ’06 and Dr. Mary Shehan are among her personal heroes. At a time of nursing shortages and hospital closures, they teach students how to square with changes in the industry while maintaining their compassion.
“I think that’s part of the draw of North Park. You get to build these relationships that stick with you throughout—and long after—your academic career,” Chmielewski said.
Creating a coalition of resources currently unavailable to disadvantaged groups helps build connections with their community and trust with healthcare providers.
North Park Recognizes Outstanding Alumni


Dr. Owen R. Youngman BA ’75, HON ’05
Distinguished Alumni Award
Owen R. Youngman comes from a family of North Parkers. In fact, he and his wife, Linda (Erlandson) Youngman NPC ’75 married in Isaacson Chapel and recently celebrated their 50th anniversary.
At the awards ceremony held during Homecoming, he reflected on his and his classmates’ time at North Park. “It prepared us for lives of significance and service in our careers, our churches, and our communities.”
Youngman is a professor emeritus
of journalism at Northwestern University, where he taught the institution’s first Massive Open Online Course. He had a 37-year career at The Chicago Tribune and played a key role in launching its website and RedEye.
Youngman also served on the Evangelical Covenant Church Executive Board, as chair of the North Park University Board of Trustees, and as chair of Libertyville Covenant Church, where he sings in the choir and has led its brass ensemble for 35 years.
Dr. Hilary Applequist BS ’00 and Greg Applequist BS ’00, MDiv ’08
Distinguished Alumni Award
Hilary and Greg Applequist met at a first-year mixer during North Park University’s Threshold in 1996 and married in 2002. They now have two children: Brooke (18), who attends North Park, and Cameron (14).
God called Hilary toward a career in nursing during her senior year. Now a palliative care nurse practitioner, she serves as an adjunct faculty member in a Bachelor of Science in Nursing to Doctor of Nursing Practice program and on the Covenant Ministries of Benevolence board.
While attending North Park, Greg participated in many programs, like the Södra Vätterbygdens Folkhögskola exchange program and CollegeLife. He is now the lead pastor at First Covenant Church of Omaha.
Hilary and Greg shared at the ceremony, “North Park gave us a strong educational foundation and enabled us to gain leadership skills and deepen our faith. These gifts have served us and others well, personally and professionally.”

Daniela Pojmaevich Jennings BA ’15, BS ’15
Distinguished Young Alumni Award
As an international student from Ecuador, North Park University sparked in Daniela Pojmaevich Jennings a love for intercultural friendships.
After graduating, she returned to Ecuador, spending seven years as the Quito Quest director with Misión Mundo Juvenil. She built short-term team experiences with local and visiting churches, assisted pastors in poverty alleviation, and ran a leadership/ discipleship program for college-aged students. Her motto, “People over projects,” guides her work.
After getting married and returning to the United States, Pojmaevich
Jennings served as the leadership pipeline director at Casa Chirilagua in Alexandria, Virginia, supporting Latino immigrant families through mentorship, education, community mobilization, and conversations exploring immigration and faith. When accepting her award, she said, “North Park instilled in me awareness of myself, God, and others. Thank you for creating spaces for learning, growth, community, and service.”
Pojmaevich Jennings lives in South Carolina with her husband, Caleb, and their son, Sebastian (1).
Rev. David F. Potter BA ’15
Distinguished Young Alumni Award
When accepting his award, David F. Potter said, “I am forever in debt to the dynamic faculty that made my time at North Park University as formative as it was. Truly, the mentorship I received changed my life.”
After graduating, Potter utilized his conflict transformation studies and mediation training in Chicago Public Schools. As a restorative justice specialist, he implemented strategies to build community and disrupt the school-to-prison pipeline.
In 2016, Potter relocated to Washington, DC, and discerned a call to ordained ministerial leadership. He became ordained in the Episcopal Church in 2022 and later created MovementPrayers.com, a collaborative resource built to empower movement chaplaincy.
He now serves the Church of the Epiphany in Washington, DC, and hosts a weekly pop-up coffee bar there. In addition to parish leadership, Potter offers spiritual direction and is writing a memoir. He and his spouse, Mary, are expecting a child this winter.
I am forever in debt to the dynamic faculty that made my time at North Park University as formative as it was. Truly, the mentorship I received changed my life.
—David F. Potter
Viking Champions Campaign
The Viking Champions Campaign, a fundraising initiative for North Park University Athletics, is a team sport that relies on everyone doing their part. This year was an outstanding victory—202 donors contributed gifts ranging from $1 to $10,000, raising $35,242.
Viking Club
Football
Baseball
Men’s soccer
Men’s basketball
Women’s soccer
Women’s volleyball
Men’s volleyball
Men’s golf
Women’s basketball
Softball
Women’s tennis
Cheer
Flag football
Athletic Training
Cross country
Track and field
Dance
$35,242 Funds raised
202 Donors

Family of Vikings
Melissa White NPU ’02 and Shawn White BS ’02 met at North Park University (NPU) and bonded over their experiences as student-athletes on the Viking soccer teams. Now, their daughter Linnea White is on the women’s soccer team herself. Shawn recalls the importance and impact of alumni who mentored him during his time at NPU, which showed him to “give back and help students how [he] can.” That’s just one reason why Shawn and Melissa invest generously today to support Viking athletics.
Team Captains
Melissa and Shawn served as team captains for this year’s Viking Champions Campaign for women’s and men’s soccer, respectively. They were joined by fellow alumni
Casey Smagala BA ’12 for football, Michael Harper BA ’80 for men’s basketball, Cindy Helwig NPC ’74 for women’s basketball, and Sue Kelly NPC ’90 for women’s volleyball. Viking Champions Campaign captains rally behind their team, leading the charge to boost support. To join the ranks next year, email the Office of Advancement at advancement@northpark.edu.
Viking Club: Gold Level
North Park University Athletics are fueled by donor support. Join fellow Viking alumni and supporters in the Viking Club: Gold Level to receive insider access. Sign up for a monthly gift of $25 or invest $250 or more annually to become a member.
Learn more and sign up.

1960s
Michael M. Kazanjian NPC ’66 has retired and resumed teaching college philosophy. He is developing a college seminar using his book Unified Philosophy: Interdisciplinary Metaphysics, Ethics, and Liberal Arts. He also received Triton College’s Outstanding Adjunct Award and Department of Behavioral Science Outstanding Adjunct Award and recently published a paper on Paul Ricoeur with implications for Christians.
1980s
Lenita (Rapp) Scholer BA ’80 lives and works in Michigan’s Upper Peninsula, enjoying life with her adult children and pets.

Steve B. Johnson BA ’81 and Jon Anderson NPC ’83 reconnected in November 2024 after 35 years. They spent a week together at Hope of Life International in Guatemala, building 1,000 chicken coops to help with sustainability and economics, enjoying each other’s company, and reminiscing on North Park memories.
Alumni Notes

Tyndale Kids published Sonja (Young) Anderson’s BA ’85 A Christmas Wish for Little Dala Horse: A St. Lucia Celebration in September.

Caron (Lazo) Igoe NPC ’89 has moved to a new home in Olympia, Washington.
1990s

After 35 years of teaching, most of them in Chicago Public Schools, Carol Uhl-Alba BA ’90 partially
retired in the fall. She is still teaching at Dominican University and recently celebrated 26 years of marriage with her husband. They have one son, Ryan Alba, who began attending North Park University in the fall.

Susan Boland Dawson MBA ’95 recently published Growing Into Leadership: Lessons Learned Along the Way, a book for current and aspiring leaders that shares the battle-tested wisdom that helped her become a transformational leader.
2000s

Marylynn Ritchie Gaastra BA ’08 and Tyler Gaastra BA ’08 welcomed daughter Genevieve Lynn Gaastra on August 28, 2024. They praise God for their healthy baby girl.

Lisa Stueckemann MNA ’09 recently published Fundraising Rebel, a book providing strategy and encouragement for fundraisers who refuse to settle for a “the way we’ve always done it” mentality. She credits her North Park University degree and more than 15 years in the nonprofit sector for providing her with this unique point of view.
2010s

Molly (Davies) Bubb BSN ’10 and husband Aaron welcomed daughter
Emerson Rae Bubb on June 5, 2025. Brother Carter (2) is thrilled to have a baby sister.

Jennifer (Bulinski) Wessels BA ’11, BS ’14, MBA ’16 recently started JAB Holistic Fitness, a consultation service for police officers looking to improve their wellness goals and had her article “The Six Facets of Holistic Wellness” published in Police Chief Magazine. She and husband Micah welcomed their first child, Amalia Elise, on June 5, 2025, in Sugar Land, Texas.

Fordham University’s Master of Arts in International Political Economy and Development program awarded Christopher Lempa BS ’18 its Arrupe Fellowship. The fellowship provides full tuition and a graduate
assistantship, supporting students committed to careers in international relief and development. While at Fordham, Lempa will serve as a programming intern with the United Nations Development Programme. Following his first year, he will complete an overseas summer field placement within the international development sector in Africa, Asia, or Latin America. The fellowship honors Father Pedro Arrupe, whose legacy inspires work for justice, peace, and refugees worldwide.

Karla Yatckoske MBA ’19 has built Uplifting Melodies Tutoring, a Chicago-based virtual education company providing shift-friendly workplace English classes for construction and manufacturing employees. It focuses on everyday language so participants can ask questions, share ideas, follow instructions, and connect with teammates.
2020s
Zayd Vestal BA ’25 received his certification to teach English as a foreign language and is now teaching in England and Greece.
Jeanne M. Lageson NPC ’47 passed away on July 17, 2025, in Apple Valley, Minnesota.
Joann E. Nordhaus A ’47 passed away on January 10, 2025, in Libertyville, Illinois.
Rev. G. M. Enns MDiv ’48 passed away on March 5, 2025, in Spring Valley, California.
Inez E. Johnson NPC ’48 passed away on August 22, 2025, in Turlock, California.
Miriam “Mim” Olson AA ’48 passed away on May 12, 2024, in Minneapolis.
Marian E. Hayes AA ’49 passed away on August 10, 2025, in Golden Valley, Minnesota.
James A. Hollensteiner A ’49 passed away on March 9, 2025, in Barrington, Illinois.
Carol E. Skahn AA ’49 passed away on July 14, 2025, in Bridgman, Michigan.
Barbara B. Miller AA ’50 passed away on July 29, 2025, in Traverse City, Michigan.
Nancy L. Novit AA ’50 passed away on March 5, 2025, in Highland Park, Illinois.
In Memoriam
Rev. J. Robert Nelson AA ’53 passed away on February 21, 2025, in Marquette, Michigan.
Dr. Charles H. Anderson AA ’54 passed away on August 4, 2025, in Ada, Michigan.
Rev. Lowell V. Drotts AA ’54 passed away on July 14, 2025, in Deer Park, Illinois. Drotts’ passions were reading and teaching, particularly the Bible. After completing his seminary studies, he took a Bible teacher position at Minnehaha Academy. Soon after, he became a pastor in the Evangelical Covenant Church in Batavia, Illinois, and later Evanston, Illinois; Chicago’s Beverly neighborhood; and Attleboro, Massachusetts. In his final eight years before retirement, Drotts served as the chaplain of Covenant Village of Northbrook.
Bruce Brantner A ’55 passed away on May 25, 2025, in LaSalle, Illinois.
Ray E. Duell NPC ’55 passed away on October 28, 2024, in Ignacio, California.
Ann C. Hanson AA ’56 passed away on May 11, 2025, in Yorktown, Indiana.
Patricia A. Hudson AA ’56 passed away on April 24, 2025, in Rock Island, Illinois.
Philip R. Humbaugh A ’56 passed away on May 11, 2025, in Wilmington, North Carolina.
John F. Jansson AA ’56 passed away on February 19, 2025, in Wilmette, Illinois.
Gail P. Schabow A ’56 passed away on June 1, 2024, in Peoria, Arizona.
Kathryn L. Forsen NPC ’57 passed away on September 17, 2025, in Rockford, Illinois.
Vernon Hultgren NPC ’57 passed away on September 17, 2025, in Carol Stream, Illinois.
Arnold S. Nelson AA ’57 passed away on May 4, 2025, in Lake Barrington, Illinois.
Clara M. Adamson BA ’60 passed away on March 13, 2025, in Trimont, Minnesota.
Edward Boba BA ’60 passed away on September 23, 2025, in Riverwoods, Illinois.
John I. Branstrom BA ’60 passed away on June 1, 2025, in New Hope, Minnesota.

Bruce P. Bickner A ’61 passed away on October 21, 2025, in Sycamore, Illinois. He was a faithful and generous alumnus who served in many capacities, including three terms on the North Park University Board of Trustees and as the board chairperson. Bickner also served as North Park’s interim president between Presidents Horner and Parkyn.
He led a distinguished career in agribusiness, serving as chairman and CEO of DEKALB Genetics Corporation and executive vice president for Monsanto. Bickner received North Park’s Distinguished Alumni Award in 1999 and was honored with the David Nyvall Medallion for Outstanding Service to North Park in 2016.
Velma J. Condreay BSN ’61 passed away on March 1, 2025, in Plantation, Florida.
James A. Lindskoog A ’61 passed away on August 29, 2025, in Brunswick, Georgia.
Priscilla H. Olson NPC ’61 passed away on April 1, 2025, in Anoka, Minnesota.
Helen L. Morlock NPC ’62 passed away on May 16, 2025, in Golden Valley, Minnesota.
Ronald C. Volk A ’62 passed away on March 3, 2025, in Park Ridge, Illinois.
Dolores Adie BA ’63 passed away on May 22, 2025, in Indianapolis.

Dr. Michael Richard Hans Swanson BA ’63 passed away on April 29, 2025, in Bristol, Rhode Island. He was a professor emeritus of Roger Williams University, where he taught from 1972 until his retirement in 2017 and created the first undergraduate degree program in historic preservation. Swanson sang in choirs all his life and loved to travel.
Dr. David L. Swanson BA ’64 passed away on April 30, 2025, in Lititz, Pennsylvania. He was inducted into the Viking Hall of Fame in 1988.
Rosalind Marie Swanson NPC ’64 passed away on August 15, 2024, in Batavia, Illinois.
James A. Facklis BA ’65 passed away on August 15, 2025, in Chicago.
Linda A. Toule NPC ’65 passed away on May 2, 2025, in Phoenix.
Warren W. Young BS ’65 passed away on June 10, 2025, in Glenview, Illinois.
Betty J. Giovenco NPC ’66 passed away on September 17, 2025, in Green Bay, Wisconsin.
Virginia M. Claassen NPC ’67 passed away on September 14, 2025, in Barrington, Illinois.
Peggy J. Monley BA ’67 passed away on April 19, 2025, in Woodland, California.
Susanne K. (Miller) Koob A ’68 passed away on August 8, 2024, in Garden Ridge, Texas.

Richard “Dick” Mahoney BA ’69 passed away June 26, 2025, in Lake Zurich, Illinois. After being honorably discharged from the United States Marine Corps, he attended North Park University and played football and baseball, winning several conference championships. After graduating from North Park, he returned to teach physical education and coach football, baseball, and wrestling. Mahoney led the wrestling team to its first-ever conference championship in 1972. He was inducted into the Viking Hall of Fame in 2015.
Paul G. Bushnell BA ’70 passed away on August 29, 2025, in Albuquerque, New Mexico.
David Douglass A ’70 passed away on March 3, 2025, in Park Ridge, Illinois.
Marie Durkin NPC ’70 passed away on September 1, 2025, in Evanston, Illinois.
Dennis P. Marton BA ’70 passed away on July 8, 2025, in Chicago.
Daniel E. Olson BA ’70 passed away on May 31, 2025, in St. Charles, Illinois.
Marcia R. Knudson A ’71, BA ’76 passed away on March 3, 2025, in Chicago.
David E. Willy NPC ’71 passed away on April 9, 2025, in Sun City, Arizona.
Jane L. Hobeika BA ’72 passed away on September 23, 2025, in Onancock, Virginia.
Rev. Paul A. Hedberg BA ’73 passed away on May 24, 2025, in Tucson, Arizona.
Janice H. Lizan BA ’74 passed away on May 28, 2025, in Hatfield, Wisconsin.
Darryl N. Johnson BA ’75 passed away on September 9, 2024, in Seattle.
Dr. Carla Lang MDiv ’76 passed away on May 17, 2025, in Winston-Salem, North Carolina.
Michael J. Thomson NPC ’78 passed away on March 25, 2025, in Green Bay, Wisconsin.
Gregory G. Zino BA ’81 passed away on January 31, 2025, in Woodstock, Georgia.
Rev. Bruce E. Thorson MDiv ’82 passed away on March 22, 2025, in Round Lake Park, Illinois.
Esther Poage Wistrom NPC ’84 passed away on October 21, 2025, in Chicago. She dedicated 35 years to caring for others as a registered nurse, primarily in the mother-baby unit, where she found great joy in helping to welcome new life into the world and supporting mothers and their newborns after delivery.
Kristen L. Dahl BA ’86 passed away on May 7, 2025, in Westbrook, Connecticut.
Rev. Alison K. Wiens-Randall BA ’87 passed away on February 23, 2025, in Columbus, Ohio.
Bernardina Vergara BA ’91 passed away on June 9, 2025, in Chicago.
Patrick F. Jops BA ’95 passed away on June 5, 2025, in Chicago.
Rev. Ethel L. Davis MA ’01 passed away on April 6, 2025, in Alsip, Illinois.
James E. Terry MM ’01 passed away on August 10, 2025, in Mesa, Arizona.
Sarah Cave BA ’08 passed away on September 12, 2025, in Mumbai, India. She attended Hillside Covenant Church, developing lifelong friendships through its youth group and summer camp, Camp Squanto. Cave studied violin from a young age and continued those studies at North Park University, where she met
mentor Dr. Tom Zelle and became the youngest member of the Civic Orchestra of Chicago.
Brenda Brooks BSN ’11, MSN ’18 passed away on August 16, 2025, in Bellwood, Illinois.
Molly R. Philosophos MNA ’12 passed away on February 12, 2025, in Milwaukee. She was a Jimmie Alford Scholarship recipient.

Vernol “Vern” A. Nordling, a devoted husband, father, servant, and friend of North Park University, passed away on August 14, 2025, in Duluth, Minnesota. Following their daughter Sharon’s graduation from North Park in 1991, Vern and his wife, May (Swanson) Nordling, faithfully supported the university’s mission. They established the Nordling Endowed Scholarship Fund and various seminary scholarships.
As a devoted Christian, Vern lived his life as an abundant thank you for the promise of everlasting life given to him. He believed in living that joy by pouring his life out to others and that every North Park graduate was equipped to “be good and do well.”
From the Archives

As beloved North Park Professor Emeritus Zenos Hawkinson reminds us, a critical need of humankind is a “living memory” that is a “matter both of head and heart.” The Covenant Archives and Historical Library—which includes the archival collections related to North Park University (NPU)—serves as a living memory for the rich heritage of NPU and the Evangelical Covenant Church (ECC).
This year, the Covenant Archives celebrates its 90th anniversary of preserving and making available to the public the stories of NPU and the
ECC, which celebrates its 140th year.
Located in the lower level of the Brandel Library, the F.M. Johnson Archives and Special Collections is the physical home for the Covenant Archives, housing thousands of documents, photographs, journals, and publications, including archival issues of the North Parker magazine, which has also reached its 90th year.
This work is made possible by hundreds of history keepers— historians, archivists, professors, students, and secretaries—who have saved, organized, described, preserved, and provided access
to records of lasting historical significance.
Of course, the mission of the archives is not boxes and books neatly arranged on the shelf; it is to serve the public by sharing these records, telling stories through exhibits and events, and hosting researchers who make these memories come alive.
As we celebrate these milestones of the Covenant Archives, ECC, and North Parker, we honor the visionary leaders who built this institution, bless the ever-growing and expanding North Park community, and look to the future with hope and confidence.
